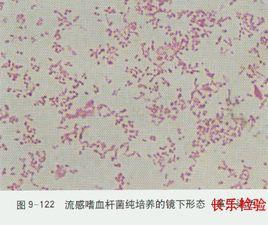
苛養菌 苛養菌

主要苛養菌介紹
嗜血桿菌屬
(1)分類
與人類密切相關的嗜血桿菌有8種,比較常見的是流感嗜血桿菌和副流感嗜血桿菌。
(2)細菌特性
嗜血桿菌培養時必須供給X、V因子,新鮮血液含X、V因子,但V因子處於抑制狀態,必須將其加熱80℃~90℃才能釋放出來,故朱古力瓊脂適合於嗜血桿菌生長。不同的嗜血桿菌對X、V因子需求有所不同。
將流感嗜血桿菌與金黃色葡萄球菌共同培養後,後者合成較多V因子,可促進流感嗜血桿菌生長,靠近金黃色葡萄球菌的流感嗜血桿菌菌落較大,反之,菌落較小,稱之為衛星現象。
(3)臨床意義
嗜血桿菌常寄居於正常人上呼吸道,可引起上呼吸道、泌尿生殖道感染、腦膜炎、中耳炎、心內膜炎、菌血症。流感嗜血桿菌主要引起原發性化膿感染和繼發性感染,其莢膜b型株毒力最強。杜克雷嗜血桿菌為軟下疳病原菌。
(4)微生物檢驗
採集腦脊液、血液、膿液、痰液、咽拭子等標本進行檢查,因苛養菌不易存活,標本宜保持濕潤,及時送檢。